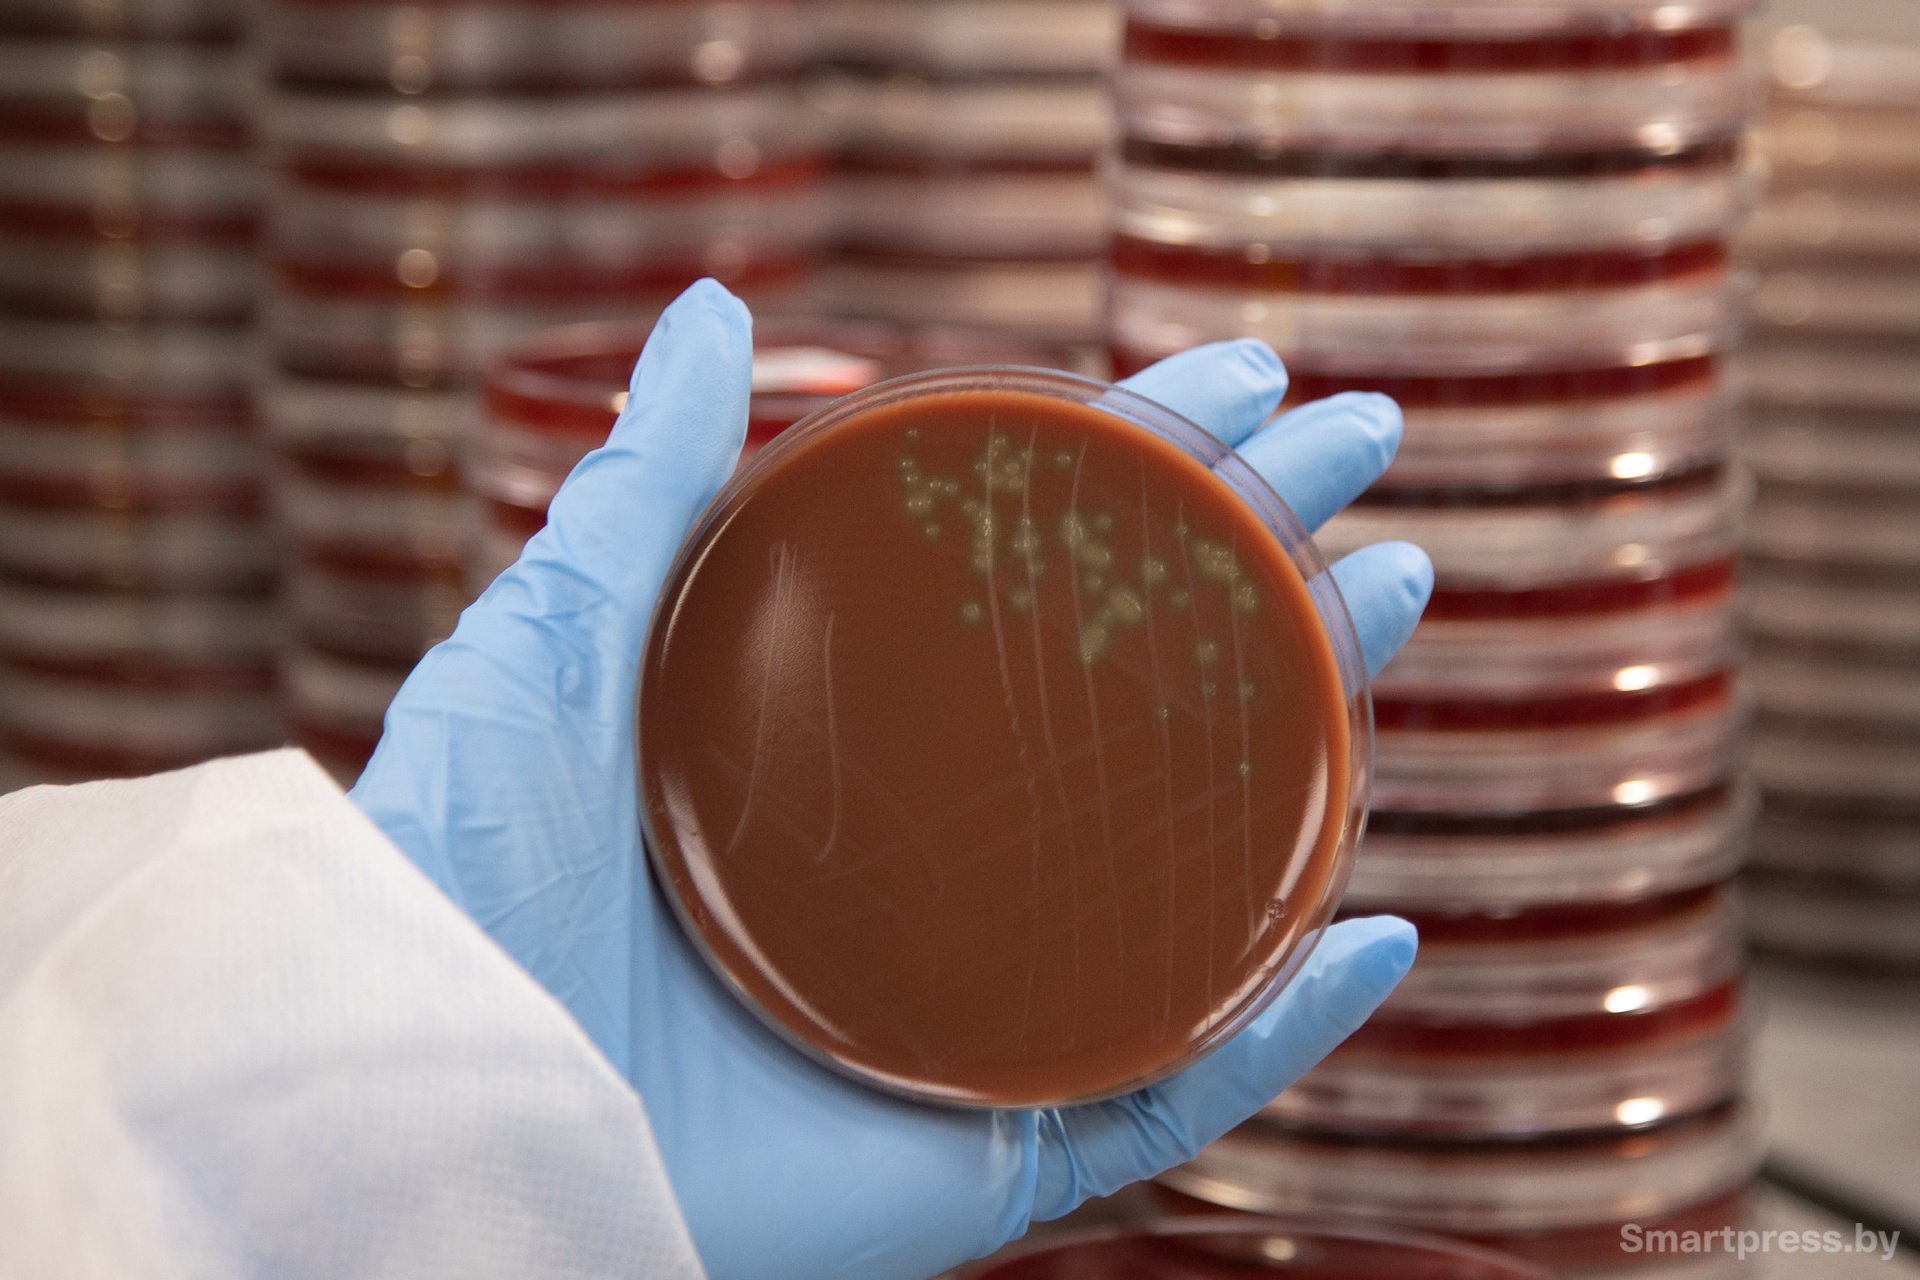
Микроорганизм в чашке Петри
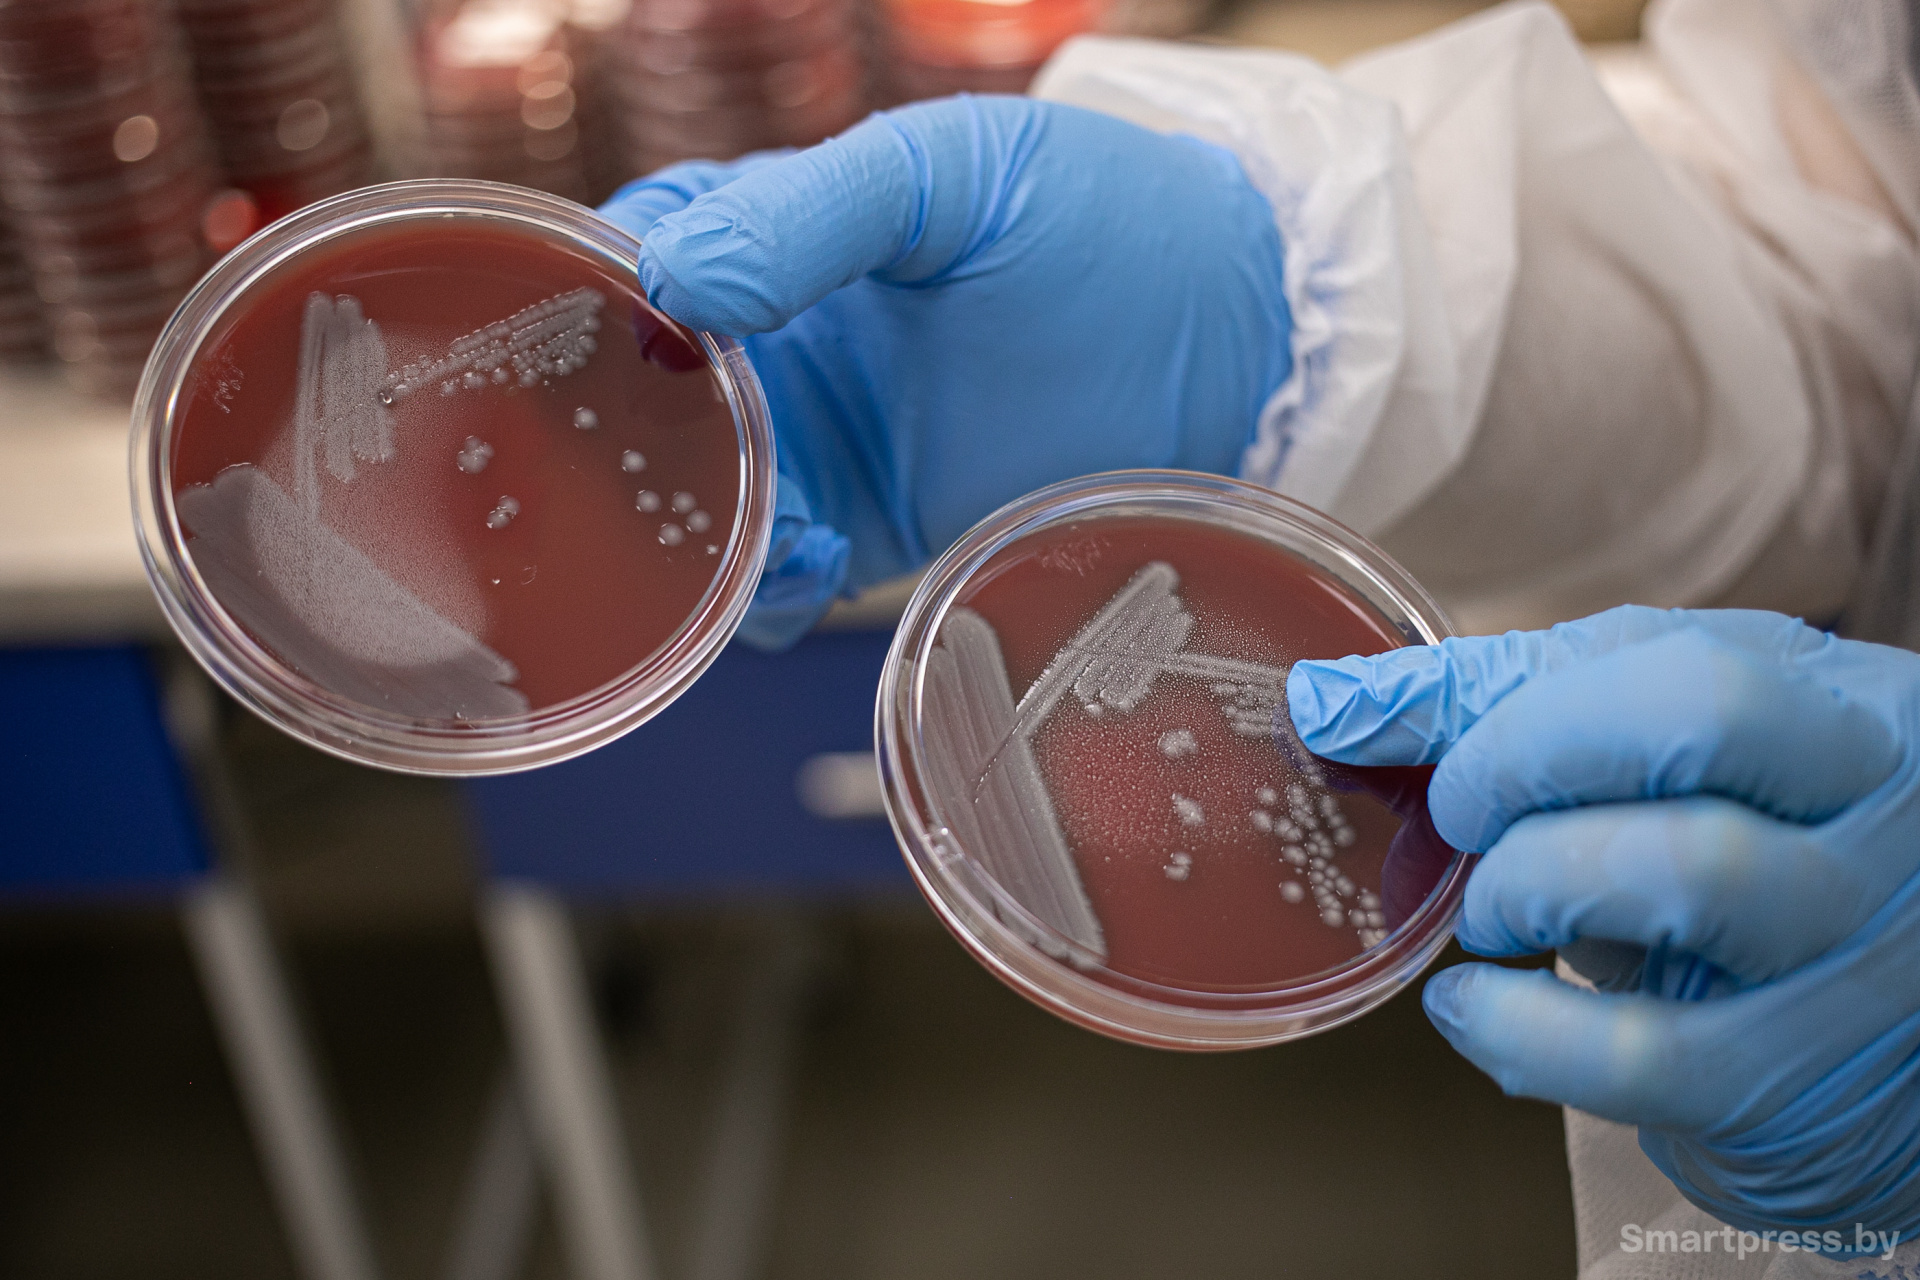
Микроорганизмы в чашке Петри
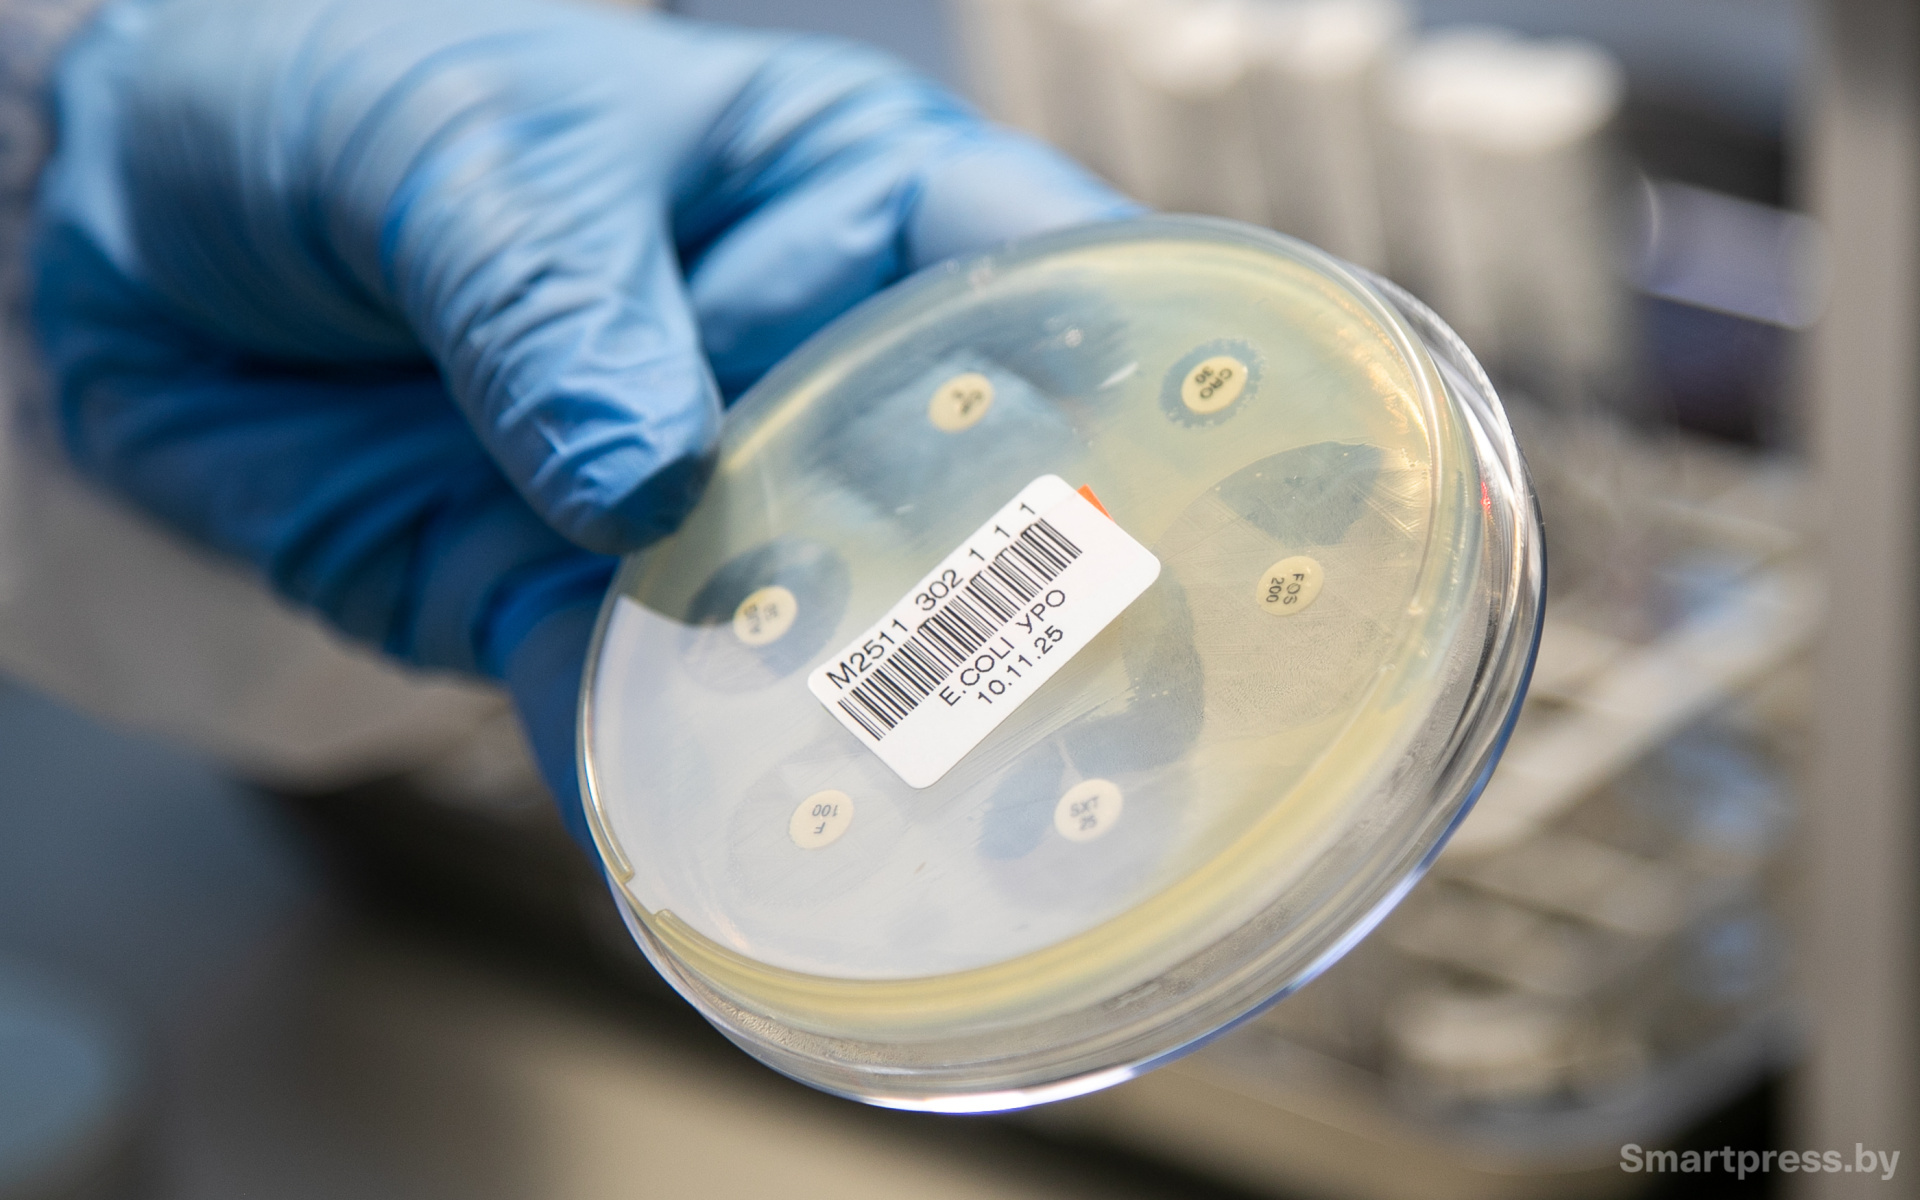
Чашка Петри

Кашель никак не проходит – может, это не банальная простуда? Снова “объявился” цистит – неужели не долечили? Чтобы “победить” болезнь, нужно понять, кто ее вызвал. Как раз этим и занимаются в международной медицинской лаборатории Helix. Нам показали, как определяют возбудителей заболеваний, и удивили тем, что некоторые бактерии можно распознать по… запаху.
 Сотрудники микробиологической лаборатории проверяют образцы
Сотрудники микробиологической лаборатории проверяют образцы
На столах – “небоскребы” из чашек Петри
Нас встречает врач клинической лабораторной диагностики, заведующий клинико-диагностической лабораторией Дарья Лукьянёнок и подводит к дверям. На них – знак биологической опасности: прямо как в фильмах про секретные исследования.
 Дарья Лукьянёнок
Дарья Лукьянёнок
Всё потому, что за дверями изучают патогенные бактерии, вирусы и грибы, которые находят в анализах. Нас одевают в халаты и бахилы и просят четко следовать инструкциям персонала.
– Helix – единственная частная лаборатория в Беларуси, которая проводит свои собственные микробиологические исследования, а не отправляет образцы сторонним организациям, – с гордостью произносит Дарья Лукьянёнок. – Тут изучают мочу, соскобы из урогенитального тракта, зева и носа, эякулят и секрет предстательной железы, отделяемое ран, глаз, ушей – методами ПЦР и бакпосева.
 Врачи-лаборанты Диана Борода и Елена Крюкова анализируют образцы с микроорганизмами
Врачи-лаборанты Диана Борода и Елена Крюкова анализируют образцы с микроорганизмами
Бактерии выращивают в “кровяной” среде
Заходим в комнату, где работают с бактериями и грибами. Тут их бережно “выращивают” в чашках Петри из биоматериала пациентов, рассказывает Дарья Лукьянёнок. На столах замечаем настоящие “небоскребы” из таких образцов.
– Начинается всё с того, что с помощью специального инструмента (петли или ватного тампона) я переношу образец из пробирки на питательную среду в чашку Петри, – делится тонкостями своей работы фельдшер-лаборант Елена Радионова.
 Пробирки с образцами, чашки Петри с питательной средой и другие рабочие инструменты
Пробирки с образцами, чашки Петри с питательной средой и другие рабочие инструменты
В глаз сразу бросается то, что среда – темно-красного цвета. Напоминает кровь – и она действительно есть в составе, правда, баранья.
– Эта красная субстанция представляет собой агар-агар с питательной средой, сделанной на основе бараньей крови (побочного продукта пищевой промышленности). Это лучший питательный субстрат для бактерий: на нем вырастают даже самые чувствительные микроорганизмы. Правда, из-за этого такая среда стоит дороже, чем остальные. Но мы всегда закупаем именно ее, чтобы быть уверенными в результатах исследований, – поясняет заведующая.
 С помощью такого инструмента лаборант переносит образец на питательную среду в чашку Петри
С помощью такого инструмента лаборант переносит образец на питательную среду в чашку Петри
Фельдшер-лаборант Елена Радионова отмечает, что для каждого образца подбирается своя среда, и показывает чашки Петри, стоящие на столе. Не во всех среда вишнево-красная – есть еще желтая, коричневая, янтарная, розово-красная. В них кроме крови или вместо нее содержатся другие питательные добавки – например, эмульсия на основе яичного желтка, казеин, мясной и дрожжевой экстракты.
– Бывает, нужно использовать не одну, а несколько сред. Поскольку в одном образце редко бывает один-единственный микроб. Зачастую там целый микромир. Всё зависит от того, откуда брали анализ. Если из зева (ротоглотки), то представляете, сколько там “жителей”, – включается в разговор врач-лаборант Елена Крюкова. – То же самое касается урогенитального тракта, где есть условно-патогенные микроорганизмы. И врач должен заранее представлять, что за они, чтобы найти среди них “злодея”, – подчеркивает сотрудница.
Разные виды питательных сред на столе лаборанта
“В 95% случаев можем определить патоген на глаз”
Далее чашки Петри помещают в термостат – прибор, который создает комфортные для роста бактерий условия. Через 24 часа врачи осматривают образцы – выросло там что-нибудь или нет. Если обнаружен рост, начинается процесс вычисления патогена.
Вот так в чашке Петри вырастает неизвестный микроорганизм, который нужно идентифицировать
Вот так в чашке Петри вырастает неизвестный микроорганизм, который нужно идентифицировать
– Сначала мы проводим визуальный осмотр. Если есть признаки роста – анализируем образец на спектрофотометре (в его программное обеспечение вшита огромная база микроорганизмов). Хотя в 95% случаев мы можем определить патоген по его размеру, форме и даже запаху. Например, синегнойная палочка, которая любит вызывать отиты, синуситы, циститы, так вкусно пахнет земляникой. Открываешь крышку – и как будто перед тобой тарелка этих ароматных ягод. Но вам придется поверить нам на слово – понюхать не дадим, – смеется врач-лаборант Диана Борода.
Таким образом на питательной среде вырастают микроорганизмы – и сотрудники могут распознать их даже по внешнему виду
Таким образом на питательной среде вырастают микроорганизмы – и сотрудники могут распознать их даже по внешнему виду
В соседней комнате стоит тот самый спектрофотометр – огромный прибор, который используют для точного определения вида патогена. Интересуемся у сотрудника, встречаются ли в ходе исследований необычные или особо опасные бактерии.
– Большинство микроорганизмов – стандартные: стафилококки, стрептококки, синегнойная палочка и др. Хотя “вырастают” и менингококки, которые вызывают менингит, и сальмонеллы, и гонококки. Ну и нетипичные бактерии тоже прибор обнаруживал, например, лактобактерии из продуктов – в урогенитальном тракте.
 Врач-лаборант Диана Борода показывает нам спектрофотометр, который точно “вычисляет” возбудителя болезни
Врач-лаборант Диана Борода показывает нам спектрофотометр, который точно “вычисляет” возбудителя болезни
Устойчивость к антибиотикам – не редкий случай, особенно у людей в возрасте
Чтобы вычислить, что за патоген атаковал организм пациента, проводят антибиотикограмму. Она позволяет определить, каким антибиотиком можно “убить” бактерию, а к каким она устойчива.
 Серия образцов, которую проверяют на устойчивость к антибиотикам
Серия образцов, которую проверяют на устойчивость к антибиотикам
Такое исследование проводят на третьи сутки, чтобы микроорганизм успел “разрастись” по всей чашке Петри равномерным цветным слоем. Затем на этот слой наносят маленькие диски с разными антибиотиками и определяют “зону просветления” – это та область, где нет характерного налета. Значит, бактерия там погибла.
– Делаем это не на глаз, а измеряем с помощью специальной линейки и сравниваем со стандартными значениями по таблице, – показывает нам Диана Борода.
 На эти маленькие кружки нанесены разные антибиотики – и если вокруг кружка нет желто-зеленого налета, то бактерия чувствительна к антибиотику
На эти маленькие кружки нанесены разные антибиотики – и если вокруг кружка нет желто-зеленого налета, то бактерия чувствительна к антибиотику
Сейчас много говорят о развитии устойчивости к антибиотикам. Это действительно проблема? Спрашиваем у врачей.
– Да, устойчивость к антибактериальным препаратам встречается часто. Особенно, если пациент уже в возрасте. Ведь обычно чем старше человек, тем больше он за свою жизнью принимал антибиотиков. Чаще всего устойчивость встречается к самому распространенному веществу – ампициллина тригидрату, – рассказывает врач-лаборант Елена Крюкова.
В этой чашке Петри бактерия оказалась устойчивой к одному из антибиотиков
В этой чашке Петри бактерия оказалась устойчивой к одному из антибиотиков
По анализу бактерия есть, а фактически – нет: как такое возможно?
В завершение разговора сотрудники лаборатории подчеркивают, что хоть они и указывают в результатах анализов подходящий вид антибиотика, не стоит заниматься самолечением: окончательное решение должен принимать врач.
– Ведь это может быть транзиторная флора – бактерия прямо перед соскобом “залетела” в нос, но так и не прижилась – погибла. По анализу у вас обнаружен стрептококк, но фактически его нет, он не вызвал болезнь. Значит, и антибиотики не нужны, – подчеркивает врач-лаборант Елена Крюкова. – Конечно, можно сдавать анализы самостоятельно, но расшифровывать их стоит только вместе с доктором.
 Врач-лаборант Елена Крюкова поясняет, что в результаты анализа может попасть “транзиторная” флора, поэтому расшифровывать их должен доктор
Врач-лаборант Елена Крюкова поясняет, что в результаты анализа может попасть “транзиторная” флора, поэтому расшифровывать их должен доктор
Место, где работают с вирусами: исследования проводят в закрытых боксах
Еще одно направление молекулярно-биологических исследований, которые выполняют в международной лаборатории Helix – это ПЦР-диагностика вирусов и бактерий. Именно тут массово определяли Covid-19, рассказывает заведующая.
– Здесь исследования проводятся в закрытых боксах: образцы не выносят за пределы помещений, а передают биоматериал через передаточные окна – от подготовки образца до конечного исследования в анализаторе, который определяет ДНК или РНК патогена.
 Таким образом выглядит помещение, где готовят образцы для ПЦР-диагностики
Таким образом выглядит помещение, где готовят образцы для ПЦР-диагностики
Вход туда запрещен – можно только подсмотреть, что происходит внутри, через прозрачные двери. Но увиденного вполне хватило, чтобы получить представление о том, как работает микробиологическая лаборатория Helix.
Нас приятно удивило, с каким вдохновением сотрудники рассказывали о своей работе: для них ежедневные исследования – не скучные рабочие будни, а увлекательные мини-расследования. А это так же важно для проведения точных и достоверных исследований, как и многолетний опыт работы.
Автор: Ирина Ивлиева, фото: Смартпресс
*Партнерский материал
*Использование и цитирование данной статьи допускается в объеме, не превышающем 20% при наличии гиперссылки. Более 20% – только с разрешения редакции.














